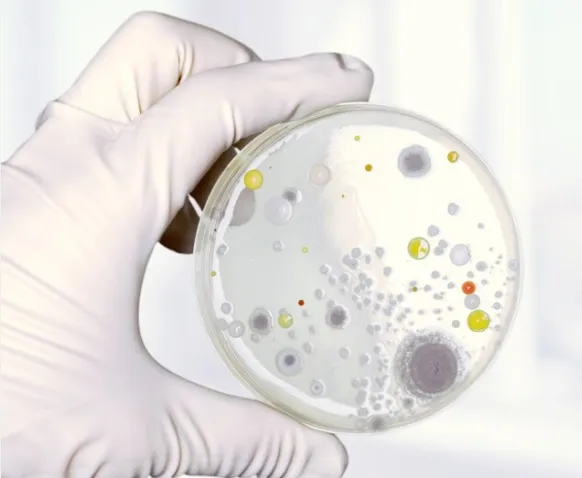

Formazione professionale in Tricologia



Webinar e contenuti aggiornati












Webinar e contenuti aggiornati


PER LA RICERCA SCIENTIFICA
"L'unico programma che valorizza la professione artigianale, inserendoli nel settore della ricerca."





Androgenetica

Androgenetica

Clicca sul Pulsante

Compila il Modulo

Ricevi le Credenziali

Giuseppe S.
"Credevo di non essere portato per la tricologia, mi sembrava troppo complicata. Ma Daniele spiega tutto in modo così chiaro che mi ha fatto appassionare. Ora mi sento sicuro nel dare consulenze reali alle clienti. E funziona: tornano e mi chiedono di più!"


Federica L.
"Il bello non è solo il contenuto, è Daniele. Ha una capacità rara: ti fa capire anche i concetti più complessi con parole semplici, esempi pratici e pure qualche battuta che ti fa sorridere. E quando impari con leggerezza, impari meglio."


Giuseppe S.
"Credevo di non essere portato per la tricologia, mi sembrava troppo complicata. Ma Daniele spiega tutto in modo così chiaro che mi ha fatto appassionare. Ora mi sento sicuro nel dare consulenze reali alle clienti. E funziona: tornano e mi chiedono di più!"


Federica L.
"Il bello non è solo il contenuto, è Daniele. Ha una capacità rara: ti fa capire anche i concetti più complessi con parole semplici, esempi pratici e pure qualche battuta che ti fa sorridere. E quando impari con leggerezza, impari meglio."


Laura M.
"Pensavo fosse il solito videocorso ‘freddo’, invece c’è una community vera, persone come me, ci si confronta, ci si aiuta. Chiara, Daniele e gli altri del Team sono super presenti, rispondono, ti motivano, ti fanno sentire parte di qualcosa di speciale."


Nino D.
"Ho fatto altri corsi, ma nessuno mi ha fatto sentire così coinvolto. Daniele ha carisma, empatia, e soprattutto... sa come farti capire le cose. La community che ha creato è un vero valore aggiunto: confronto, supporto e ispirazione."




1
2
3
Clicca sul Pulsante
Compila il Modulo
Ricevi le Credenziali

Clicca sul Pulsante

Compila il Modulo

Ricevi le Credenziali
Assolutamente. Acquisirai competenze che la maggior parte dei parrucchieri non ha, diventando un vero punto di riferimento per cute e capelli.
È pensato per chi lavora in salone: ogni lezione è pratica, collegata ai problemi reali che vedi ogni giorno.
Sì, il corso è pensato per parrucchieri: spieghiamo tutto in modo chiaro, semplice e concreto, senza linguaggio da medici.
È molto più di un’infarinatura: ti dà solide basi e competenze spendibili per costruirti un’identità professionale come tricologo/a del capello.
Certo! Puoi guardarlo quando vuoi, da qualsiasi dispositivo, senza limiti.
Sì! È un videocorso pratico, visivo e spiegato passo-passo. Niente mattoni teorici, solo contenuti utili e chiari.
